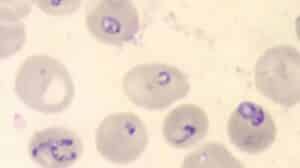
BABESIOA CDC IMAGE bmicrotiDPDx

In our Babesia 2006 foundation textbook, still ahead of current frozen approaches, we mention tafenoquine as a possible great new option to treat Babesia.
And when it was available, wise infection physicians used it for malaria. As the only new malaria drug in 60 years and as a long acting drug it was exceptional. But now it is almost impossible to get.
Tafenoquine is a long acting primaquine. So how high can we dose primaquine?
Epelboin, et. al., reports 14 day use of 2 primaquine a day (or 15 mg x 2 or 30 mg) did not have risks. 1
If Babesia reproduces 30x a month is it long enough to think 14 days is a cure? We did not see a decrease with any treatment in 14 days of any treatment.
Babesia in Red Blood Cells
CDC.gov
Primaquine has the potential to reduce malaria-related anaemia at day 42 and beyond by preventing recurrent parasitaemia. 2
If it is used widely, this will require ruling out G6PD deficiency–to reduce the risk of drug-induced haemolysis in vulnerable individuals. 2
I think that many nations have high numbers of individuals with G6PD deficiency and do not have easy access to testing the G6PD status. In the USA testing for G6PD is simple, even though USA physicians have no Babesia training or expertise in the required tests like G6PD and effective doses.
The transmission blocking dose of primaquine previously recommended was 0.75 mg/kg (adult dose 45 mg) but its deployment was limited because of concerns over haemolytic effects in patients with glucose-6-phosphate dehydrogenase (G6PD) deficiency. 3 But this is a five minute test and easily ruled out as a concern. 3
Lengthening of the Q-T interval is a definite outcome when patients are administered with an overdose of primaquine… [and can cause] arrhythmias. 4
1. Valdes A, Epelboin L, Mosnier E, Walter G, Vesin G, Abboud P, Melzani A, Blanchet D, Blaise N, Nacher M, Demar M, Djossou F. Primaquine 30 mg/day versus 15 mg/day during 14 days for the prevention of Plasmodium vivax relapses in adults in French Guiana: a historical comparison. Malar J. 2018 Jun 19;17(1):237. doi: 10.1186/s12936-018-2378-2. PMID: 29921273; PMCID: PMC6009032.
2. Commons RJ, Simpson JA, Thriemer K, Chu CS, Douglas NM, Abreha T, Alemu SG, Añez A, Anstey NM, Aseffa A, Assefa A, Awab GR, Baird JK, Barber BE, Borghini-Fuhrer I, D’Alessandro U, Dahal P, Daher A, de Vries PJ, Erhart A, Gomes MSM, Grigg MJ, Hwang J, Kager PA, Ketema T, Khan WA, Lacerda MVG, Leslie T, Ley B, Lidia K, Monteiro WM, Pereira DB, Phan GT, Phyo AP, Rowland M, Saravu K, Sibley CH, Siqueira AM, Stepniewska K, Taylor WRJ, Thwaites G, Tran BQ, Hien TT, Vieira JLF, Wangchuk S, Watson J, William T, Woodrow CJ, Nosten F, Guerin PJ, White NJ, Price RN. The haematological consequences of Plasmodium vivax malaria after chloroquine treatment with and without primaquine: a WorldWide Antimalarial Resistance Network systematic review and individual patient data meta-analysis. BMC Med. 2019 Aug 1;17(1):151. doi: 10.1186/s12916-019-1386-6. PMID: 31366382; PMCID: PMC6670141.
3. Bancone G, Chowwiwat N, Somsakchaicharoen R, Poodpanya L, Moo PK, Gornsawun G, Kajeechiwa L, Thwin MM, Rakthinthong S, Nosten S, Thinraow S, Nyo SN, Ling CL, Wiladphaingern J, Kiricharoen NL, Moore KA, White NJ, Nosten F. Single Low Dose Primaquine (0.25 mg/kg) Does Not Cause Clinically Significant Haemolysis in G6PD Deficient Subjects. PLoS One. 2016 Mar 24;11(3):e0151898. doi: 10.1371/journal.pone.0151898. PMID: 27010542; PMCID: PMC4807095.
4. Kim KS, Lee HA, Cha SW, Kwon MS, Kim EJ. Blockade of hERG K(+) channel by antimalarial drug, primaquine. Arch Pharm Res. 2010 May;33(5):769-73. doi: 10.1007/s12272-010-0517-6. Epub 2010 May 29. PMID: 20512476.




